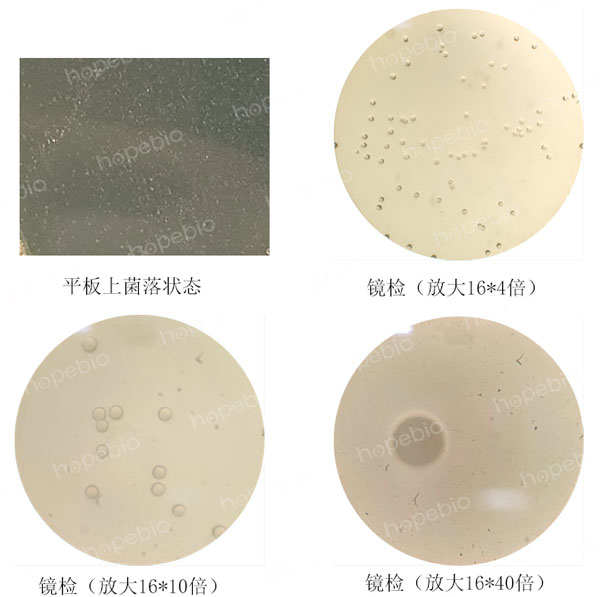
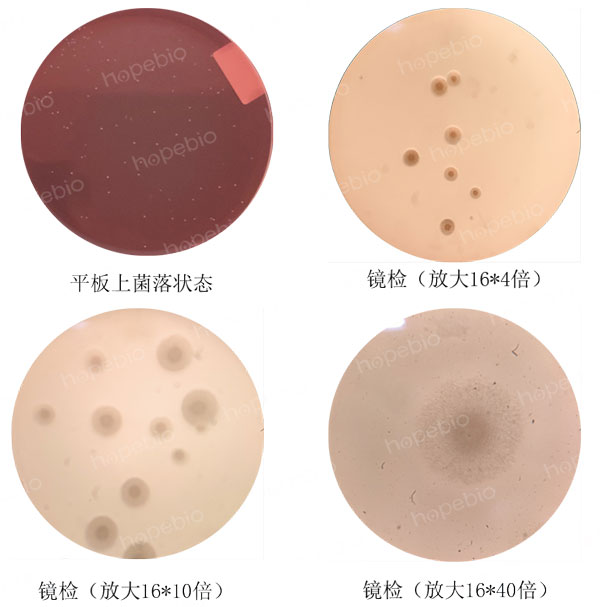
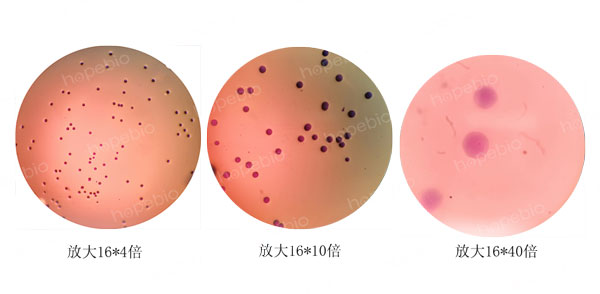

海博微信公众号
海博微信公众号
 海博天猫旗舰店
海博天猫旗舰店


 海博微信公众号
海博微信公众号
 海博天猫旗舰店
海博天猫旗舰店




一、支原体简介
支原体结构简单,缺乏细胞壁,仅有质膜,胞体内有核蛋白体以及一个由环形双链DNA分子组成的原核。支原体大小仅有0.1μm~0.3μm,最小直径约为100nm,可通过细菌滤器,会干扰细胞培养等工作的进行。由于其能形成丝状与分枝形状,故称为支原体。
不同支原体利用的能源物质不同,如肺炎支原体、人型支原体等可发酵葡萄糖,口腔支原体可水解精氨酸,还有解脲支原体可利用尿素作为能源。我们可通过发酵葡萄糖、水解精氨酸、水解尿素等生化反应鉴别支原体。
支原体营养要求一般比细菌高,除必须的基础营养物质外,还需添加10%~20%的动物血清以提供支原体所需的助生长因子。由于大多数的支原体兼性厌氧,有些菌株在活化分离时保持5%~10%二氧化碳环境生长状态更好。解脲支原体在厌氧条件下生长更好。
支原体无细胞壁,对渗透压敏感,对抑制细胞壁合成的抗生素不敏感,因此可添加青霉素抑制细菌的生长。由于渗透压突变会导致支原体破裂死亡,因此培养支原体时,维持适宜的渗透压显得格外重要。此外,在支原体培养中,pH也是重要因素。
支原体在固体平板培养基上的菌落状态为煎蛋状,这种菌落状态也是因为支原体没有细胞壁的缘故,支原体向培养基内部生长形成“蛋黄”部分,支原体在培养基表面生长便形成了“蛋清”部分。
二、肺炎支原体、口腔支原体检验依据及原理
人肺炎支原体检查法在2020年版《中华人民共和国药典》中体现,要求使用支原体肉汤培养基(货号为HB7025-2,可参考文章支原体肉汤培养基的原理和使用方法)培养监测肺炎支原体。具体操作要求为:将肺炎支原体稀释至10-7~10-9,接种在支原体肉汤培养基中,每个稀释度接种3支试管,置于36℃培养7-14天,观察培养基变色结果。肺炎支原体可以发酵培养基中的葡萄糖,使培养基的pH值降低,遇指示剂酚红使培养基变黄。
猪肺炎支原体检查的方法在中国药典中无具体要求,我们可以参照人肺炎支原体检查法。
口腔支原体检查法在2020年版《中华人民共和国药典》中体现,要求使用精氨酸支原体肉汤培养基(货号为HB7025-5)培养监测口腔支原体。具体操作要求为:将口腔支原体稀释至10-3~10-5,接种在精氨酸支原体肉汤培养基中,每个稀释度接种3支试管,置于36℃培养7-14天,观察培养基变色结果。口腔支原体可以利用培养基中的精氨酸,使培养基pH值升高,遇指示剂酚红使培养基变红。
三、支原体固体平板培养的方法
1.取活化的人肺炎支原体(活化支原体的方法可参照视频:肺炎支原体的灵敏度试验方法)、猪肺炎支原体分别接种至支原体肉汤中,并进行10倍梯度稀释,涂布适宜浓度的稀释液100μL至支原体琼脂固体平板上(货号为HB7025-3),封口膜包住平板边缘以提供微需氧环境且能有效避免一定的污染,直到培养至光线下可以看到针尖大小的菌落,人肺炎支原体在平板上及镜检下的菌落状态如图1所示。
图1 人肺炎支原体在平板上及镜检下的菌落状态
猪肺炎支原体在平板上及镜检下的菌落状态如图2所示。

图2 人肺炎支原体在平板上及镜检下的菌落状态
2.取活化的口腔支原体接种至精氨酸支原体肉汤中,并进行10倍梯度稀释,涂布适宜浓度的稀释液100μL至支原体琼脂固体平板上(使用货号为HB7025-1;较HB7025-3不同点在于含精氨酸和酚红),封口膜包住平板边缘以提供微需氧环境且能有效避免一定的污染,直到培养至光线下可以看到针尖大小的菌落,口腔支原体在平板上及镜检下的菌落状态如图3所示。
图3 口腔支原体在平板上及镜检下的菌落状态
四、支原体染色方法及染色后镜检结果
为了增加颜色的对比度,更好的观察检测支原体,可采用加染色液的方法对支原体进行染色,染色还可有效排除气泡的干扰。中国药典采用的为指示细胞培养法即DNA染色法,需要借助特殊的荧光染料和荧光显微镜进行观察。而一般的实验室并不具备这样的条件,因此可以使用更为简单的染色方法,借助两种常用的染料及普通电子显微镜即可观察。具体步骤为:将蕃红染液或结晶紫染液(革兰氏染色A液;HB8278)稀释一定的倍数,直接加入到平板上染色10秒,之后用水冲洗掉,无需切割琼脂块,直接将平板放置于显微镜观察,人肺炎支原体的染色镜检结果如图4所示。
图4 人肺炎支原体的染色镜检结果
猪肺炎支原体的染色镜检结果如图5所示。

图5 猪肺炎支原体的染色镜检结果
口腔支原体的染色镜检结果如图6所示。

图6 口腔支原体的染色镜检结果
五、注意事项
支原体染色镜检方法可参考视频:口腔支原体固体平板法及染色镜检,该视频详细展示了固体平板的制备方法及注意细节。
相关产品:
上一篇:鉴定类培养基的检验方法
下一篇:常用样品、菌株稀释液选择
| 相关文章: | |
| 成人肺炎克雷伯菌败血症53例临床分析 | |



